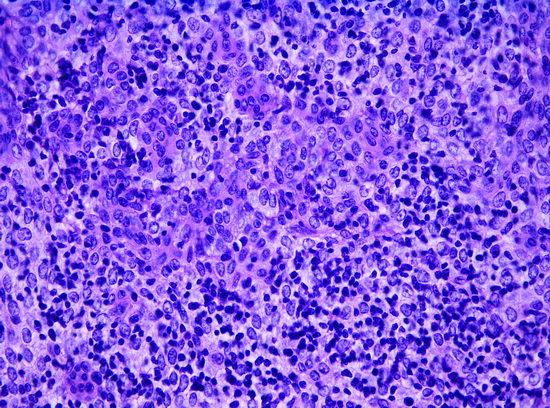

Миастения при опухолях вилочковой железы
Стоногин В.Д.
(Центральная клиническая больница Министерства путей сообщения Российской Федерации)
Опухоли вилочковой железы (тимомы) среди оперированных по поводу миастении по данным литературы встречаются от 8-12% до 20% и более (М.И. Кузин с соавт., А.В. Тарасов с соавт. и др.).
Среди оперированных в клинике за 30 лет (1968-1999) 708 больных по поводу миастении опухоли наблюдались у 137 больных, что составляет 19,3%. У 57 больных опухоль отнесена к доброкачественным, 80 – злокачественным. Мужчин было 62, женщин – 75. Большинству из оперированных удалось произвести радикальную операцию, у 3 она носила паллиативный характер, одна больная не была оперирована.
Больная К., 35 лет, переведена в клинику из миастенического центра 1.07.99 для решения вопроса об операции. Жалобы на слабость, быструю утомляемость, гнусавость голоса, опущение век, двоение в глазах. Больна около 1 года. Наблюдалась по месту жительства (г. Есентуки Ставропольского края), затем направлена в миастенический центр в г. Москву. При поступлении общее состояние больной удовлетворительное, телосложение правильное, питание удовлетворительное. Лицо амимичное. Опущение верхнего века слева. Сила в руках и в ногах снижена. Голос слегка гнусавый. Рентгенологическое исследование грудной клетки: в легких патологических образований не выявлено; в передне-среднем средостении слева определяется мягкотканное образование с бугристой поверхностью округлой формы размером 9х4,5х4 см, оно полностью не отделяется от головки корня левого легкого; помимо этого имеется еще два образования: на плевре по левой среднеключичной линии на уровне первого ребра образование 4х2,3х2 см и в центре левого купола диафрагмы гантелевидное образование 7х4,5х2,8 см. Компьютерная томография: в передне-верхнем средостении определяется опухолевидное образование с бугристыми контурами размером 6х7 см, которое интимно прилежит к верхнему отделу средостения, интимно связано с сердечной сорочкой по левому контуру; верхний край левого легкого поджат; бифуркационные и паратрахеальные узлы увеличены, во II-ом межреберье слева определяется образование на широком основании мягкотканной консистенции, которое прилежит к плевре, на диафрагмальной поверхности плевры определяется опухолевое образование в диаметре около 3 см. Заключение: дифференциальный диагноз должен проводится между лимфогранулематозом и опухолью вилочковой железы с метастазами по плевре.
Больной проведена торакоскопия, при которой подтверждено наличие множественных опухолевых образований на париетальной плевре. Произведена биопсия опухолевых образований плевры. При гистологическом исследовании получен ответ: злокачественная лимфоэпителиальная тимома. Наличие злокачественной лимфоэпителиальной тимомы с множественными метастазами по плевре явилось противопоказанием к хирургическому лечению. Для химио- и лучевого лечения больная переведена в онкологический институт.
Чем же отличаются больные миастенией при опухолях от других больных, у которых процесс неопухолевый – персистирующий тимус,

Рис 1 - Персистирующий тимус. Гистологическое исследование
гиперплазия элементов вилочковой железы?

Рис 2 - Гиперплазия вилочковой железы. Макропрепарат вилочковой железы после тимэктомии
Опухоли чаще наблюдаются у лиц среднего и старшего возраста. До 30 лет опухоль нами наблюдалась всего у 12 больных, от 31 года до 50 лет – у 80 больных, старше 50 – у 40 больных. Некоторые авторы указывают, что у больных с опухолями непродолжительный анамнез, с этим можно согласиться, у большинства наших больных анамнез был коротким, но мы наблюдали больных и с длительным анамнезом.
Пример. Больная С.,51 года, агроном, жительница о. Сахалин. В клинику поступила с жалобами на слабость, быструю мышечную утомляемость, гнусавость голоса, поперхивание при еде, опущение век, похудание. Больна более 5 лет, обращалась к врачам по месту жительства, диагноз был поставлен только через 3 года от начала заболевания. Было назначено лекарственное лечение, которое оказывало недостаточных эффект. Для операции направлена в г. Москву с диагнозом миастения генерализованная. При обследовании общее состояние больной средней тяжести. Лицо амимичное, голос гнусавый, веки опущены, небольшая одутловатость лица. Сила в руках и ногах снижена. Рентген: справа довольно плотно прилежит к задне-правой стенки сердца округлая тень дополнительного образования овальной формы с четкими контурами размером 7х7 см, пульсирующее одновременно со стенкой сердца (возможно, передаточная пульсация). Компьютерная томография. Заключение: опухолевое образование переднего средостения (тимома). Эхокардиография: клапанный аппарат неизменен, дилатации полостей и утолщения стенок сердца не выявлено. За правым предсердием определяется однородное образование, вдающееся в полость правого предсердия. Анализ крови: Эр.-4,2; Гб.-150, Цп-0,97; Л.-4,300;Пя-1,Ся-50, Эоз.-1, Лмфц.-45,Мц-3, СОЭ-15.
11.11.98 операция трансстернальным доступом. Обнаружено: опухоль больших размеров 7х8х10 см, с ровной четкой поверхностью, интимно прилежит к правым отделам сердца. Образование овально-округлой формы, плотное, исходит из левой доли вилочковой железы. Произведена тимомтимэктомия. При срочном цитологическом исследовании получен ответ – лимфоэпителиальная тимома
Рис 3 - Лимфоэпителиальная тимома. Гистологическое исследование
При плановом гистологическом исследовании получен ответ – тимома с медуллярно-клеточной дифференцировкой, прорастающая в капсулу (вторая степень злокачественности). В правой доле картина лимфофолликулярной гиперплазии. Послеоперационный период протекал без осложнений. Рана зажила первичным натяжением. Для дальнейшего химиолучевого лечения больная переведена в онкологическое учреждение. Проведено 3 курса лечения. Через год самочувствие больной удовлетворительное.
Трудно утверждать, когда же у больной возникла опухоль. Возможно, первоначально у больной была гиперплазия элементов вилочковой железы, а затем в левой доле произошла трансформация ее в злокачественную опухоль. Маловероятно, чтобы злокачественная опухоль у больной существовала 5 лет, не прорастая в соседние органы, не давая метастазов, не вызывая значительной компрессии соседних органов.
Диагностика тимом при миастении в большинстве случаев возможна, но не всегда проста. В прежние годы исследование больного в условиях пневмомедиастинума – пневмомедиастинотомографии в большинстве случаев позволяла поставить правильный диагноз. В последние годы применение компьютерной томографии позволило полностью заменить пневмомедиастинотомографию, метод хотя и простой, но, все-таки, инвазивный.
Компьютерная томография имеет ряд преимуществ перед пневмомедиастинотомографией, он безопасен, в руках специалиста обладает большой разрешающей способностью. Процент достоверных результатов, по нашим данным, достигает 92 %, конечно, когда речь идет об опухолях небольшого размера. В далеко зашедшей стадии, когда уже имеется синдром компрессии верхней полой вены и другие признаки, диагноз облегчается. Но в этих случаях помочь больному бывает очень трудно, а чаще, просто невозможно.
Для тимомы характерно более тяжелое состояние больного и быстро прогрессирующее ухудшение состояния в связи с нарушением функции жизненно важных органов – дыхания, глотания, жевания и др. А прием антихолинэстеразных препаратов оказывает недостаточно полный эффект.
Диагноз тимомы удается поставить на основании клинических данных, их особенностей (средний и пожилой возраст, острое начало, быстро прогрессирующее течение, недостаточный эффект от лекарственного лечения) и данных рентгенологического исследования, включая компьютерную томографию.
Опыта применения таких методов исследования, как флебография вилочковой железы мы не имеем.
Основным методом лечения больных с опухолями вилочковой железы является хирургический – удаление вилочковой железы с опухолью. И, чем раньше будет выполнено хирургическое вмешательство, тем лучше, так как нередко опухоль имеет инвазивный рост, вовлекая в процесс жизненно важные органы, из-за чего опухоль оказывается нерезектабельной.
Пример. Больной Л.,26 лет, инженер. В клинику поступил с жалобами на слабость, быструю мышечную утомляемость, гнусавость голоса, двоение в глазах. Болен около 1 года. Обследован по месту жительства и в миастеническом центре (г. Москва). При поступлении общее состояние больного удовлетворительное. Правильного, атлетического сложения, хорошего питания. Лицо амимичное, голос гнусавый. Сила в руках и ногах снижена. Электрокардиограмма в норме.
Рентген грудной клетки: в легких очаговых изменений нет, корни не расширены, структурны. В переднем средостении определяется дополнительное образование размером около 11х6х4 см с бугристым наружным контуром, прилежащее к передней стенке восходящей аорты. Заключение: образование в переднем средостении, вероятнее всего, тимома. КТ по техническим причинам не производилась.
14.07.99. операция. Стернотомия. При ревизии обнаружено больших размеров образование в переднем средостении, плотное, бугристое, прорастающее в органы переднего средостения – в перикард, правую плевру, в корень правого легкого. Опухоль "вколоченная", неподвижная. Произведена биопсия. Получен ответ – светлоклеточная тимома. Операция на этом закончена. Опухоль признана неудалимой. Послеоперационный период протекал тяжело с явлениями миастенического криза. Однако применением консервативных мероприятий удалось снять явления криза. Для дальнейшего лечения больной переведен в онкологический институт. Из всех оперированных с тимомой больных у 3 опухоль, как и приведенном выше наблюдении, оказалась неудалимой. У остальных операция была радикальной.
При операции по поводу тимомы необходимо удалять не только опухоль, но и обязательно, удалять всю вилочковую железу, и, по возможности, всю жировую клетчатку переднего средостения. Если при гистологическом исследовании опухоль оказывается злокачественной, после операции больного после снятия с раны операционных швов, необходимо перевести в специализированное онкологическое учреждение для химио- и лучевого лечения.
Среди оперированных по поводу миастении с опухолью вилочковой железы мы наблюдали несколько больных, у которых опухоль была настолько небольших размеров, что вся железа выглядела как нормальная для возраста пациента. Однако на операции был выявлен злокачественный процесс.
Пример. Больной М., 30 лет. В клинику поступил 3.10.91. с жалобами на слабость, быструю мышечную утомляемость, двоение в глазах, гнусавость голоса, опущение век. Болен 1 год. Обследован в миастеническом центре. Установлен диагноз – миастения генерализованная, для операции переведен в клинику. На выполненной пневмомедиастинотомограмме вилочковая железа небольших размеров со всех сторон окутана газом, плотность ткани железы неоднородная. На операции 10.10.91. обнаружено: вилочковая железа небольшая (вес ее оказался 20 г), в нижнем полюсе левой доли небольшой участок более плотной, чем вся железа ткани, размером 1х1,5 см. при срочном цитологическом исследовании (Н.А. Шапиро) и плановом гистологическом (А.М. Чарный) получен ответ – злокачественная лимфоэпителиальная тимома. После операции больной прошел 3 курса химио- и лучевого лечения, осмотрен через 5 лет, состояние удовлетворительное. Лекарства принимает непостоянно, работает.
При операции по поводу миастении с тимомой должна быть удалена не только опухоль вилочковой железы, но и вся вилочковая железа (ее остатки), и, по возможности, жировая клетчатка переднего средостения. В противном случае может быт рецидив опухоли и рецидив миастении.
Пример. Больная А., 46 лет, медсестра из подмосковного города Пушкино. С тяжелой формой миастении поступила в клинику 12.06.68. При исследовании в условиях пневмомедиастинума в переднем средостении выявлена опухоль 14х12х10 см. Больная оперирована трансплевральным доступом. Удалена опухоль. При гистологическом исследовании опухоль оказалась тимомой, доброкачественной лимфоэпителиальной. Послеоперационный период протекал без осложнений. Через 2 недели после операции выписана из клиники. К моменту выписки явления миастении значительно уменьшились, а, затем, и совсем прошли. Через 1 год после операции она стала выполнять свою прежнюю работу медсестры. Но через 10 лет после операции 15.06.78 больная в клинику поступила повторно с жалобами на слабость, быструю мышечную утомляемость. Констатирован рецидив всех миастенических симптомов, которые были до операции. При клинико-рентгенологическом обследовании вновь выявлена опухоль переднего средостения. 20.06.78 произведена повторная операция теперь уже трансстернальным доступом. Удалена опухоль размером 8х9х9х см, плотная, бугристая, в капсуле, гистологически картина сходная с той, которая уже была 10 лет тому назад. Вероятно, при первой операции трансплевральным доступом была удалена только опухоль вилочковой железы без удаления самой вилочковой железы. В оставшейся железистой ткани через 10 лет вновь развилась опухоль. При повторной операции была удалена не только опухоль, но и вся железа, и жировая клетчатка переднего средостения. Ошибка допущена была по причине недостаточного опыта. Это была одна из первых наших операций. В дальнейшем, все операции мы выполняли только трансстернальным доступом, который позволяет произвести хорошую ревизию и удалить опухоль, вилочковую железу и прилежащую жировую клетчатку переднего средостения.
Больше подобных ошибок мы не допускали, но нам приходилось оперировать аналогичных больных повторно, первую операцию которым выполнили в другом лечебном учреждении. Так была оперирована больная, у которой удалена одна доля с опухолью, а другая доля была оставлена. Явления миастении у больной не прошли. Через 6 месяцев больная поступила в нашу клинику и была оперирована повторно. Удалена оставшаяся доля вилочковой железы с прилежащей жировой клетчаткой. Явления миастении в ближайшее время после радикальной операции прошли полностью.
У всех оперированных по поводу тимомы больных опухоль локализовалась в теле одной из долей, или в телах обеих долей, или в каком-либо из нижних полюсов справа или слева. Ни у одного больного опухоль не исходила из верхних полюсов железы. Поэтому мы считаем, что при тимоме шейный доступ не является рациональным. Рациональным доступом следует считать стернотомию, частичную или, по показаниям, полную.
Ранний послеоперационный период у больных миастенией с опухолью вилочковой железы протекает тяжелее, чем у больных с гиперплазией железистой ткани.
Чаще наблюдается миастенический криз, требующий многодневной искусственной вентиляции легких, трахеостомии, интенсивной терапии, включая современные методы детоксикации и др.
Опыта лучевой терапии (облучение вилочковой железы до операции) мы не имеем. Но нам приходилось оперировать больных, которым в других лечебных учреждениях проведено лучевое лечение. В таких случаях операция выполняется в технически белее сложных условиях, а каких-либо преимуществ больные с дооперационным облучением перед больными, которые такого облучения не проходили, нет.
Другое дело, когда имеется миастения с тимомой у пожилого больного 60-70 лет с рядом сопутствующих заболеваний и риск операции у такого больного слишком высок, он просто не перенесет операцию. Таким больным целесообразно назначить лучевое лечение, отказавшись от операции. В дальнейшем, может быть, некоторым из них при улучшении общего состояния удастся выполнить радикальную операцию. Большинству же в оперативном лечении приходится отказывать.
В ближайшем послеоперационном периоде умерли 4 больных, оперированных по поводу тимомы из 134 оперированных (послеоперационная летальность составила 3%). В то время как среди оперированных с другими изменениями вилочковой железы на последние 560 оперированных умер 1 больной (летальность - 0,17%).
Таким образом, больные с миастенией при опухоли вилочковой железы представляют наиболее тяжелый контингент больных с быстрым прогрессированием процесса, трудно поддающейся лекарственному лечению, нередко сопровождающемуся бульбарными расстройствами. Все это требует максимальной мобилизации сил, как лекарственного лечения, так и другого. Операции по поводу миастении с опухолью должны выполняться наиболее опытными хирургами в специализированном учреждении, а анестезиолого-реанимиционная служба должна быть максимально мобилизована на профилактику возможных осложнений в раннем послеоперационном периоде.
Литература
К статье Стоногина В.В. " МИАСТЕНИЯ ПРИ ОПУХОЛЯХ ВИЛОЧКОВОЙ ЖЕЛЕЗЫ".
- Кузин М.И., Шкроб О.С., Голубков В.А., Ипполитов И.Х., Шагал Д.И. – "Опухоли вилочковой железы с миастеническим синдромом".//Вестн. Хир. им. И.И. Грекова, - 1983 г. №4 с. 11-15.
- Тарасов В.А., Шахов В.А., Азаров П.И., Побегалов В.С., Ставровецкий Е.Б., Кондрашов И.А., Жидков К.П., Блюм М.В., Андреасян А.Г. –" Диагностика и лечение новообразований средостения"//Доклад на II-ом международном конгрессе по торакальной хирургии. Болонья. Италия. Июнь 1998 г. тезисы на англ. Языке.
Данные об авторе:
Василий Дмитриевич Стоногин
Кандидат медицинских наук, доцент кафедры хирургии N2 Российской медицинской академии последипломного образования
143400 Красногорск, Железнодорожная 28А 24
тел 490-10-79
e-mail: svas70@mail.ru